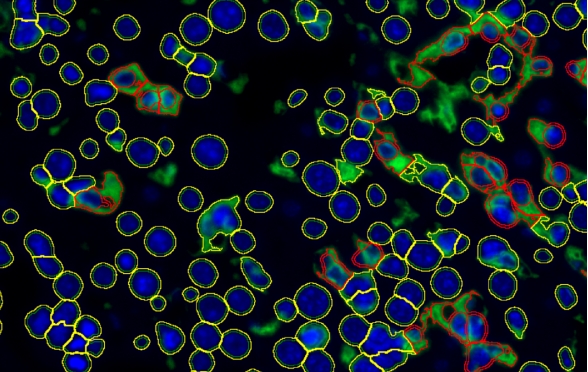

产品展示
关于Tissue Cytometry技术
奥地利TissueGnostics(TG)公司,致力于开发组织原位单细胞影像定量分析整体解决方案,研发能够服务于科研人员、辅助临床进行疑难杂症诊断、组织原位药物靶点筛选的工具。TG公司始终紧贴实际需求,自成立之初就和欧洲各大科研院所、企业建立广泛且深入的合作,不断解决一线科研人员的问题,在组织图像量化技术上积累了丰富的经验。具有的Tissue Cytometry 技术在业界为用户提供了从影像到分析的多方面解决方案,解决了图像数据,特别组织图像难以准确定量和可信度低的痛点。
Tissue Cytometry技术利用完全自动化的全景组织细胞扫描系统,建立包含上千万细胞信息的多张虚拟切片样本,结合了流式细胞术中利用二维散点图进行细胞筛选分群的信息架构方法,不但可以获得组织原位分子结构、细胞结构、组织结构的定量信息,还可以对其在空间位置上的互相关系信息进行数字化定量,并在大数据水平进行模式分析。
Tissue Cytometry技术不但可以实现以核酸分子为对象的精准定量分析需求,也可以满足在一张组织切片上同时分析核酸、蛋白、单细胞水平的形态与关系、组织器官结构的相互作用与数据验证。
核酸分子水平
比较常用的例如FISH、RNAScope等荧光分子探针标记技术,需要通过荧光分子探针的数量,实现核酸表达情况的量化分析;使用空间转录组技术,不但可以在原位检测更多的基因水平表达,也可以在组学水平获得更多的细胞表型数据。Tissue Cytometry技术在这些前置技术的结果基础上,进一步扩大了可量化分析的组织细胞面积,更可以获得表达不同基因型细胞的真实空间作用关系,丰富了空间转录组学的”空间”概念。
单细胞蛋白水平
精准识别复杂组织中的:
l 细胞结构标记(细胞核、细胞质、细胞膜等)
l 细胞亚水平结构标记物(细胞器、细胞骨架等)
l 分子探针标记(FISH、RNA Scope等)
单细胞结构标记(细胞核、细胞质、细胞膜等)
基于神经网络(DNN)与深度学习的单细胞识别算法
Tissue Cytometry技术在单细胞核识别算法基础上,结合深度神经网络算法(Deep Neural Networks,DNN),开发了新一代基于AI的单细胞核识别方法,不但可以更准确分辨互相挤压重叠的细胞核,而且对于细胞轮廓边界识别,排除了非焦面的模糊边界带来的不确定性,提高了细胞核/质/膜形态学识别的准确率。
细胞质形态学识别及定量分析
在细胞核识别的基础上,通过核周有效信号的同步扩张性算法模型,识别有效的细胞质形态。
单细胞正反向回溯验证
Tissue Cytometry技术实现从实验数据准确反向回溯到影像中的细胞。反向回溯的特征可以用来检测原位细胞亚群。通过调节核的尺寸,面积和灰度值完成软件分析。反向回溯实时观察创建的阳性细胞散点图。
组织学水平
通过AI人工智能训练,Tissue Cytometry技术可以对样本中各种独特的组织器官结构进行自动识别统计,不限于传统病理染色如HE、MASSON、PAS等等标记的组织结构特征,更可以通过识别细胞、细胞核形态,对细胞进行分类后,进一步获取细胞-组织结构形态标记的精准量化分析数据。
空间分布
组织多色空间表型分析肿瘤微环境
mIHC/IF 能够研究肿瘤微环境内细胞分布模式、肿瘤免疫抗原呈递过程中不同表型的免疫细胞互相作用模式、肿瘤细胞间位置关系、细胞骨架在细胞内外的分布情况等等,为肿瘤的早期诊断及治疗提供更具价值新思路。
显微镜主要技术参数

型号配置

友情链接:
Copyright © 杭州百赛惟思生物科技有限公司 All rights reserved. 腾云建站仅向商家提供技术服务 网站地图